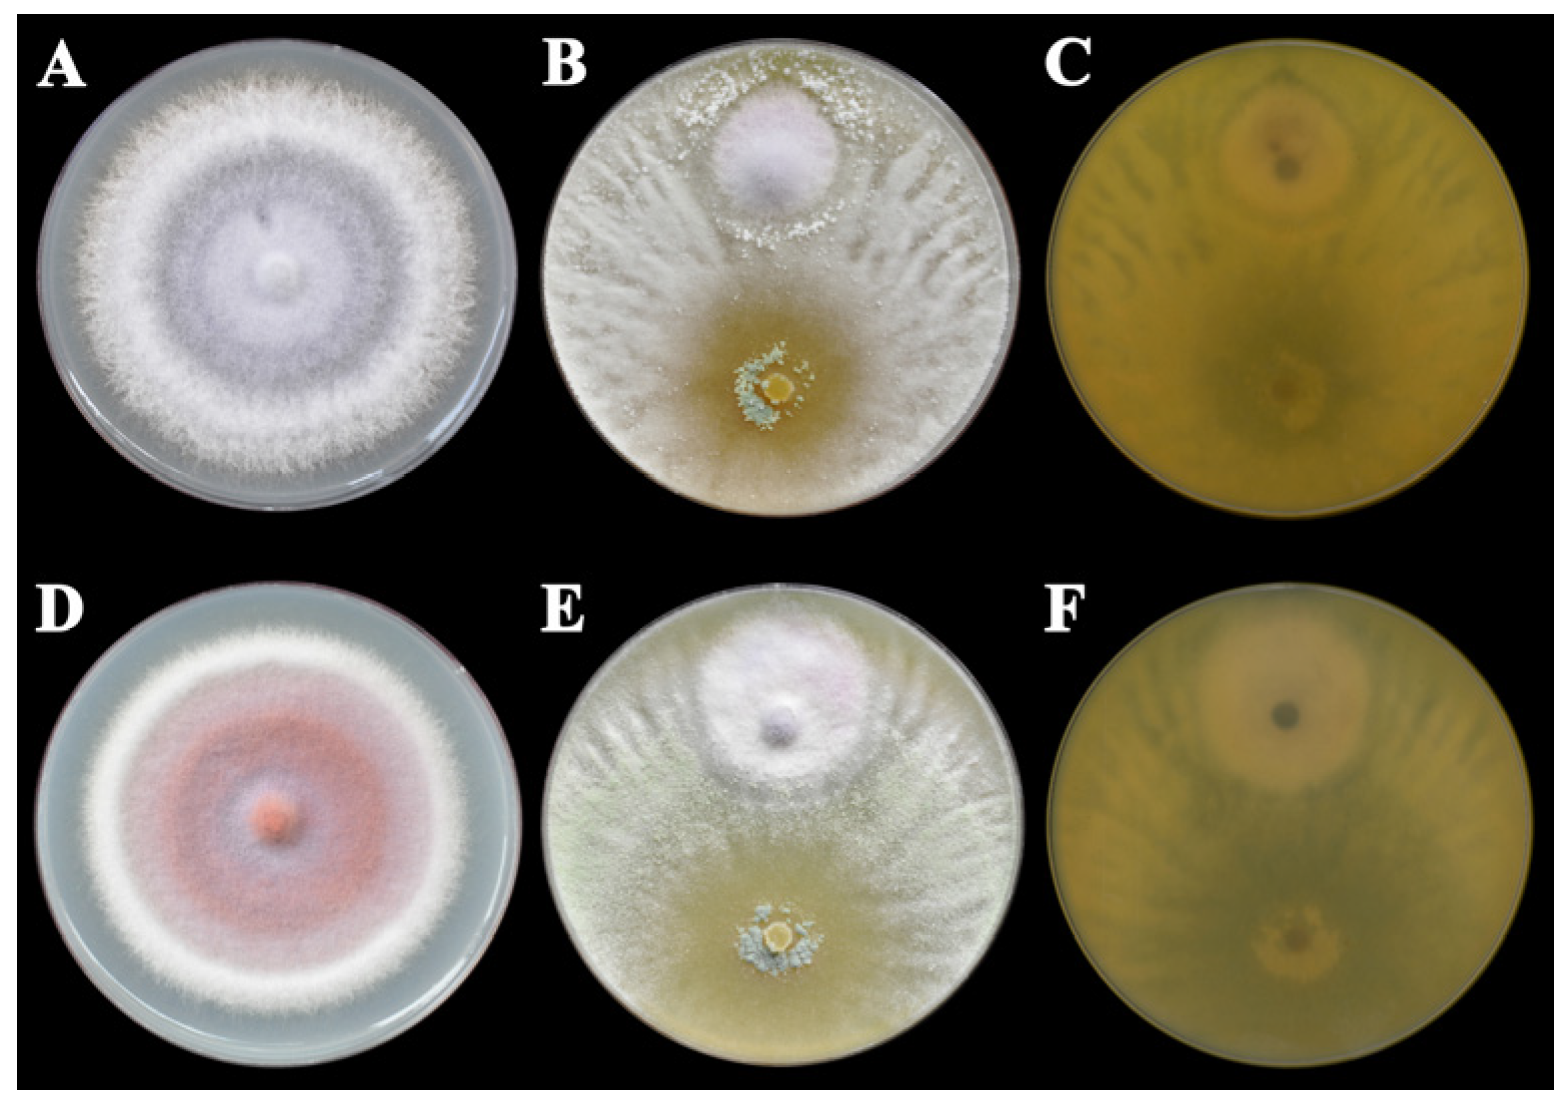
Horticulturae 11 00660 g001
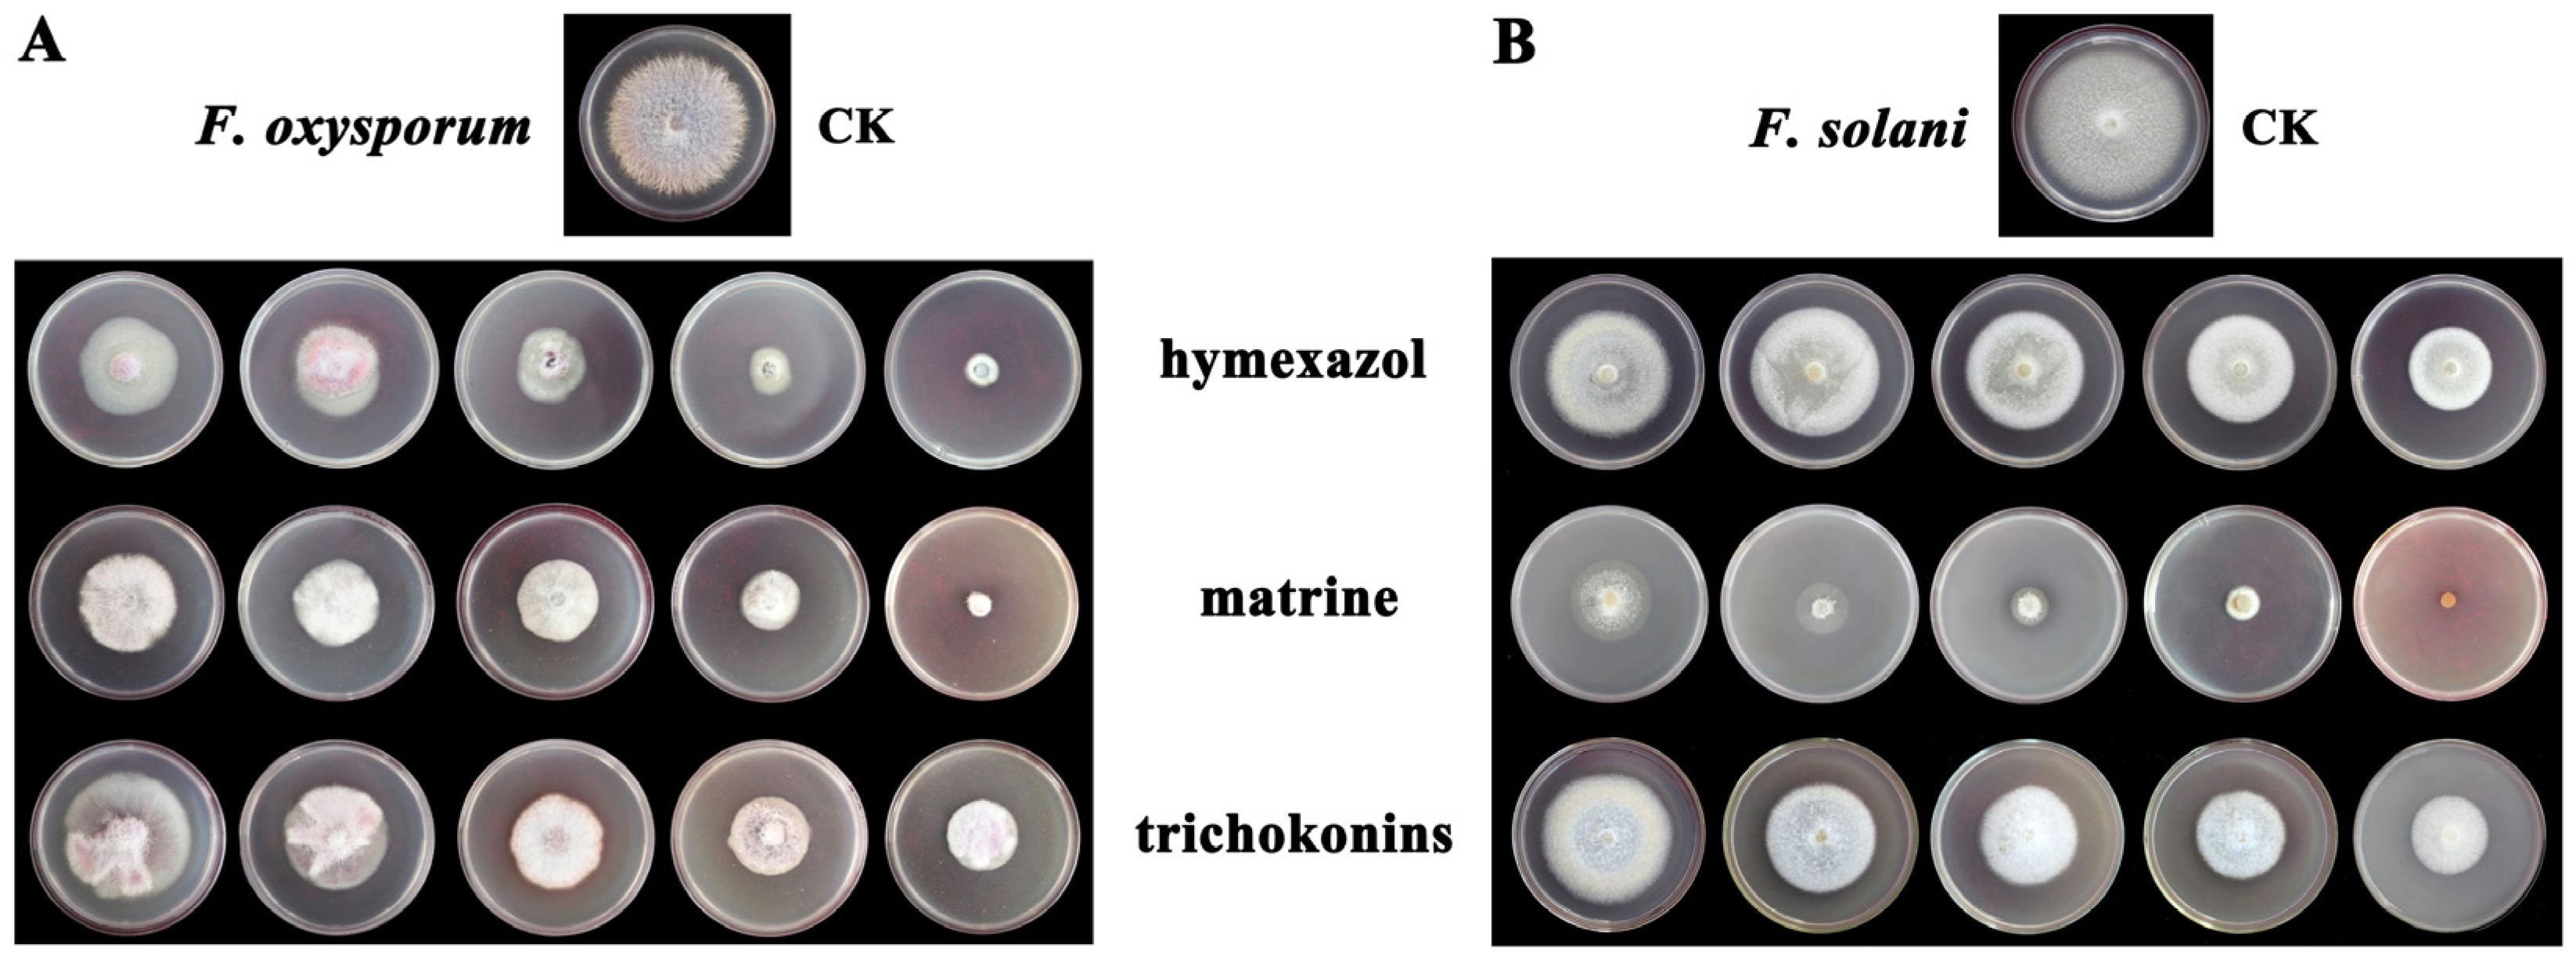
Horticulturae 11 00660 g002

Biocontrol Mechanisms of Trichoderma longibrachiatum SMF2 Against Lanzhou Lily Wilt Disease Caused by Fusarium oxysporum and Fusarium solani
Abstract
1. Introduction
2. Materials and Methods
2.1. Dual Cultures of TlSMF2 Against F. oxysporum or F. solani
2.2. Indoor Toxicity Test of TKs on F. oxysporum and F. solani
2.3. Control Efficiency of TlSMF2 Against Wilt Disease in Potting Experiments
2.4. Transcriptome Analysis from TKs-Treated Lanzhou Lily Plants
2.5. Measurement of Defense-Related Physiological Indicators
2.6. Determination of Immune-Related Genes Expression by Quantitative Real-Time PCR (qPCR)
2.7. Isolation of the LzWRKY26 Promoter and Cis-Element Analysis
2.8. Statistical Analysis
3. Results
3.1. In Vitro Colony Growth Inhibition of TlSMF2 Against F. oxysporum and F. solani
3.2. Indoor Toxicity Effect of TKs on F. oxysporum and F. solani
3.3. Biocontrol Effect of TlSMF2 Against Lanzhou Lily Fusarium Wilt In Vivo
3.4. Functional Enrichment Analysis of DEGs in Response to TKs Treatment
3.5. TKs Treatment Induced JA and SA Accumulation to Regulate Lanzhou Lily Fusarium Wilt Resistance
3.6. TKs Treatment Increased the Activity Levels of Chitinase and PAL
3.7. LzWRKY75 and LzWRKY26 Were Induced by TKs Treatment
4. Discussion
5. Conclusions
Supplementary Materials
Author Contributions
Funding
Data Availability Statement
Conflicts of Interest
References
- Cao, X.; Zhang, M.S.; Zhang, X.S.; Yu, S.C.; Zhao, P.B.; Hou, D.; Zhou, Y.R.; Song, X.Y.; Zhang, Y.Z. First report of Fusarium redolens causing root and bulb rot disease on lanzhou lily (Lilium davidii var. unicolor) in China. Plant Dis. 2020, 104, 583. [Google Scholar] [CrossRef]
- Bian, X.R.; Shi, G.Y.; Liang, Q.L.; Sun, H.Q.; Fan, S.F.; Chen, J.L. Isolation and identification of wilt disease pathogen from Lanzhou lily and its pathogenicity. J. Gansu Agric. Univ. 2016, 51, 58–64. (In Chinese) [Google Scholar]
- Straathof, T.P.; van Tuyl, J.M. Genetic variation in resistance to Fusarium oxysporum f. sp. lilii in the genus Lilium. Ann. Appl. Biol. 1994, 125, 61–72. [Google Scholar] [CrossRef]
- Lim, J.H.; Rhee, H.K.; Kim, Y.J.; Lim, K.B.; van Tuyl, J.M. Resistance to Fusarium oxysporum f.sp. lilii in Lilium. Acta Hort 2003, 620, 311–318. [Google Scholar] [CrossRef]
- LaMondia, J.A. Fusarium wilt of tobacco. Crop Prot. 2015, 73, 73–77. [Google Scholar] [CrossRef]
- Cianchetta, A.N.; Davis, R.M. Fusarium wilt of cotton: Management strategies. Crop Prot. 2015, 73, 40–44. [Google Scholar] [CrossRef]
- An, Z.H.; Huang, D.Y.; Shi, Y.X.; Li, B.J. Studies on Fungicides Controlling Lily Root Fusarium oxysporum f.sp. lilii. China Veg. 2010, 18, 23–26. (In Chinese) [Google Scholar]
- Tu, J.; Zhao, X.; Yang, Y.R.; Yi, Y.J.; Wang, H.Y.; Wei, B.Y.; Zeng, L.B. Two Bacillus spp. Strains Improve the Structure and Diversity of the Rhizosphere Soil Microbial Community of Lilium brownii var. viridulum. Microorganisms 2023, 11, 1229. [Google Scholar] [CrossRef]
- Zhang, S.; Lou, T.; Wu, S.; Liu, S.G.; Pan, H.; Yang, J.; Su, Y.F.; Hu, W.; Xiang, W.; Pan, S.Y.; et al. Bacillus velezensis GX1 and its potential for the control of lily bulb rot. Biol. Control 2024, 198, 105616. [Google Scholar] [CrossRef]
- Wang, C.C.; Ye, X.J.; Ng, T.B.; Zhang, W.J. Study on the Biocontrol Potential of Antifungal Peptides Produced by Bacillus velezensis against Fusarium solani That Infects the Passion Fruit Passiflora edulis. J. Agr. Food Chem. 2021, 69, 2051–2061. [Google Scholar] [CrossRef]
- Howell, C.R. Mechanisms employed by Trichoderma species in the biological control of plant diseases: The history and evolution of current concepts. Plant Dis. 2003, 87, 4–10. [Google Scholar] [CrossRef] [PubMed]
- Liu, Y.; Shi, A.Q.; Chen, Y.; Xu, Z.H.; Liu, Y.X.; Yao, Y.L.; Wang, Y.M.; Jia, B.L. Beneficial microorganisms: Regulating growth and defense for plant welfare. Plant Biotechnol. J. 2025, 23, 986–998. [Google Scholar] [CrossRef] [PubMed]
- Innocenti, G.; Roberti, R.; Piattoni, F. Biocontrol ability of Trichoderma harzianum strain T22 against Fusarium wilt disease on water-stressed lettuce plants. BioControl 2015, 60, 573–581. [Google Scholar] [CrossRef]
- Sallam, N.M.A.; Eraky, A.M.I.; Sallam, A. Effect of Trichoderma spp. on Fusarium wilt disease of tomato. Mol. Biol. Rep. 2019, 46, 4463–4470. [Google Scholar] [CrossRef] [PubMed]
- Zhao, P.B.; Ren, A.Z.; Dong, P.; Sheng, Y.S.; Chang, X.; Zhang, X.S. The antimicrobial peptaibol trichokonin IV promotes plant growth and induces systemic resistance against Botrytis cinerea infection in moth orchid. J. Phytopathol. 2018, 166, 346–354. [Google Scholar] [CrossRef]
- Guzmán-Guzmán, P.; Kumar, A.; de los Santos-Villalobos, S.; Parra-Cota, F.I.; Orozco-Mosqueda, M.d.C.; Fadiji, A.E.; Hyder, S.; Babalola, O.O.; Santoyo, G. Trichoderma Species: Our Best Fungal Allies in the Biocontrol of Plant Diseases—A Review. Plants 2023, 12, 432. [Google Scholar] [CrossRef]
- Lv, H.; Zhang, S.W.; Ma, N.; Boamah, S.; Xu, B.L. Trichoderma longibrachiatum (T6) Peptaibols Inhibiting the Monilia yunnanensis Growth and Inducing Pear Fruit Resistance in Its Infection. Antioxidants 2024, 13, 1517. [Google Scholar] [CrossRef]
- Song, X.Y.; Shen, Q.T.; Xie, S.T.; Chen, X.L.; Sun, C.Y.; Zhang, Y.Z. Broad-spectrum antimicrobial activity and high stability of trichokonins from Trichoderma koningii SMF2 against plant pathogens. FEMS Microbiol. Lett. 2006, 260, 119–125. [Google Scholar]
- Zhang, Y.Q.; Zhang, S.; Sun, M.L.; Su, H.N.; Li, H.Y.; Liu, K.; Zhang, Y.Z.; Chen, X.L.; Cao, H.Y.; Song, X.Y. Antibacterial activity of peptaibols from Trichoderma longibrachiatum SMF2 against gram-negative Xanthomonas oryzae pv. oryzae, the causal agent of bacterial leaf blight on rice. Front. Microbiol. 2022, 13, 1034779. [Google Scholar]
- Shi, M.; Chen, L.; Wang, X.W.; Zhang, T.; Zhao, P.B.; Song, X.Y. Antimicrobial peptaibols from Trichoderma pseudokoningii induce programmed cell death in plant fungal pathogens. Microbiology 2012, 158, 166–175. [Google Scholar] [CrossRef]
- Luo, Y.; Zhang, D.D.; Dong, X.W.; Zhao, P.B.; Chen, L.L.; Song, X.Y.; Chen, X.L.; Shi, M.; Zhang, Y.Z. Antimicrobial peptaibols induce defense responses and systemic resistance in tobacco against tobacco mosaic virus. FEMS Microbiol. Lett. 2010, 313, 120–126. [Google Scholar] [CrossRef] [PubMed][Green Version]
- Li, H.Y.; Luo, Y.; Zhang, X.S.; Shi, W.L.; Gong, Z.T.; Shi, M.; Chen, L.L.; Chen, X.L.; Zhang, Y.Z.; Song, X.Y. Trichokonins from Trichoderma pseudokoningii SMF2 induce resistance against gram-negative Pectobacterium carotovorum subsp. carotovorum in Chinese cabbage. FEMS Microbiol. Lett. 2014, 354, 75–82. [Google Scholar] [PubMed]
- He, X.; Li, W.; Zhang, W.; Jin, X.; Shenkute, A.G.; Aynalem, T.; Xu, S.; Wang, W. Transcriptome Sequencing Analysis Provides Insights Into the Response to Fusarium oxysporum in Lilium pumilum. Evol. Bioinform. 2019, 15, 1176934319838818. [Google Scholar] [CrossRef] [PubMed]
- Chang, N.N.; Zheng, L.L.; Xu, Y.; Wang, C.; Li, H.; Wang, Y. Integrated transcriptomic and metabolomic analysis reveals the molecular profiles of dynamic variation in Lilium brownii var. viridulum suffering from bulb rot. Front Genet. 2024, 15, 1432997. [Google Scholar]
- Di, X.T.; Takken, F.L.; Tintor, N. How Phytohormones Shape Interactions between Plants and the Soil-Borne Fungus Fusarium oxysporum. Front. Plant Sci. 2016, 7, 170. [Google Scholar] [CrossRef]
- Roychowdhury, R.; Hada, A.; Biswas, S.; Mishra, S.; Prusty, M.R.; Das, S.P.; Ray, S.; Kumar, A.; Sarker, U. Jasmonic acid (JA) in plant immune response: Unravelling complex molecular mechanisms and networking of defence signalling against pathogens. J. Plant Growth Regul. 2025, 44, 89–114. [Google Scholar] [CrossRef]
- Tian, H.N.; Xu, L.; Li, X.; Zhang, Y.L. Salicylic acid: The roles in plant immunity and crosstalk with other hormones. J. Integr. Plant Biol. 2024, 67, 773–785. [Google Scholar] [CrossRef]
- Miao, W.H.; Ge, L.J.; Wang, Y.A.; Li, S.; Sun, D.J.; Liu, Y.; Guan, Z.Y.; Chen, S.M.; Fang, W.M.; Chen, F.D.; et al. Overexpression of CmWRKY8-1–VP64 Fusion Protein Reduces Resistance in Response to Fusarium oxysporum by Modulating the Salicylic Acid Signaling Pathway in Chrysanthemum morifolium. Int. J. Mol. Sci. 2023, 24, 3499. [Google Scholar] [CrossRef]
- Zhang, Z.; Jiang, C.Y.; Cui, C.; Su, K.; Lin, H.; Zhao, Y.H.; Guo, Y.S. VvWRKY5 enhances white rot resistance in grape by promoting the jasmonic acid pathway. Hortic. Res. 2023, 10, uhad172. [Google Scholar] [CrossRef]
- Wang, Z.; Deng, J.; Liang, T.T.; Su, L.L.; Zheng, L.L.; Chen, H.J.; Liu, D.Q. Lilium regale Wilson WRKY3 modulates an antimicrobial peptide gene, LrDef1, during response to Fusarium oxysporum. BMC Plant Biol. 2022, 22, 257. [Google Scholar] [CrossRef]
- Li, S.; Hai, J.; Wang, Z.; Deng, J.; Liang, T.T.; Su, L.L.; Liu, D.Q. Lilium regale Wilson WRKY2 Regulates Chitinase Gene Expression During the Response to the Root Rot Pathogen Fusarium oxysporum. Front. Plant Sci. 2021, 12, 741463. [Google Scholar] [CrossRef] [PubMed]
- Vaghela, B.; Vashi, R.; Rajput, K.; Joshi, R. Plant chitinases and their role in plant defense: A comprehensive review. Enzym. Microb. Technol. 2022, 159, 110055. [Google Scholar] [CrossRef] [PubMed]
- Zhao, L.; Liu, Y.S.; Wang, M.; Xiang, L.; Wang, H.Y.; Chen, X.S.; Jiang, H.; Yin, C.M.; Mao, Z.Q. MdWRKY20-MdPR1 module mediates resistance of apple to Fusarium solani. Fruit. Res. 2025, 5, e001. [Google Scholar] [CrossRef]
- Hu, X.; Puri, K.D.; Gurung, S.; Klosterman, S.J.; Wallis, C.M.; Britton, M.; Durbin-Johnson, B.; Phinney, B.; Salemi, M.; Short, D.P.G.; et al. Proteome and metabolome analyses reveal differential responses in tomato-Verticillium dahliae-interactions. J. Proteom. 2019, 207, 103449. [Google Scholar] [CrossRef]
- Wang, L.J.; Guo, D.Z.; Zhao, G.D.; Wang, J.Y.; Zhang, S.X.; Wang, C.; Guo, X.Q. Group IIc WRKY transcription factors regulate cotton resistance to Fusarium oxysporum by promoting GhMKK2-mediated flavonoid biosynthesis. New Phytol. 2022, 236, 249–265. [Google Scholar] [CrossRef]
- Deng, J.; Wang, Z.E.; Li, W.Y.; Chen, X.H.; Liu, D.Q. WRKY11 up-regulated dirigent expression to enhance lignin/lignans accumulation in Lilium regale Wilson during response to Fusarium wilt. J. Integr. Agric. 2024, 23, 2703–2722. [Google Scholar] [CrossRef]
- Liu, D.M.; He, J.; Li, Q.; Zhang, X.; Wang, Y.S.; Sun, Q.G.; Wang, W.H.; Zhang, M.L.; Wang, Y.L.; Xu, H.S.; et al. A WRKY transcription factor confers broad-spectrum resistance to biotic stresses and yield stability in rice. Proc. Natl. Acad. Sci. USA 2025, 122, e2411164122. [Google Scholar] [CrossRef]
- Wang, R.; Wang, G.L.; Ning, Y. PALs: Emerging Key Players in Broad-Spectrum Disease Resistance. Trends Plant Sci. 2019, 24, 785–787. [Google Scholar] [CrossRef]
- He, T.T.; Shi, G.Y.; Su, G.L.; Yang, H.Y.; Li, M.Q.; Li, T.X. Function of allyl isothiocyanate esters in the control of Lanzhou lily wilt disease. J. Gansu Agric. Univ. 2024, 5, 93–101. (In Chinese) [Google Scholar]
- Cao, X.; Sui, J.J.; Li, H.Y.; Yue, W.X.; Liu, T.; Hou, D.; Liang, J.H.; Wu, Z. Enhancing heat stress tolerance in Lanzhou lily (Lilium davidii var. unicolor) with Trichokonins isolated from Trichoderma longibrachiatum SMF2. Front. Plant Sci. 2023, 14, 1182977. [Google Scholar]
- Liu, J.F.; Ding, J.; Yuan, B.F.; Feng, Y.Q. Magnetic solid phase extraction coupled with in situ derivatization for the highly sensitive determination of acidic phytohormones in rice leaves by UPLC-MS/MS. Analyst 2014, 139, 5605–5613. [Google Scholar] [CrossRef] [PubMed]
- Cao, X.; Ding, L.P.; Liang, J.H.; Zhou, Y.R.; Chen, X.L.; Li, H.Y.; Liu, T.; Yue, W.X.; Sui, J.J.; Jiang, L.B.; et al. LzSCL9, a Novel GRAS Transcription Factor in Lanzhou Lily (Lilium davidii var. unicolor), Participates in Regulation of Trichokonins-Primed Heat Stress Tolerance. Plants 2024, 13, 2330. [Google Scholar] [PubMed]
- Livak, K.J.; Schmittgen, T.D. Analysis of relative gene expression data using real-time quantitative PCR and the 2−ΔΔCT Method. Methods 2001, 25, 402–408. [Google Scholar] [CrossRef] [PubMed]
- Xu, S.j.; Chen, R.Z.; Zhang, X.Q.; Wu, Y.F.; Yang, L.Y.; Sun, Z.Y.; Zhu, Z.T.; Song, A.P.; Wu, Z.; Li, T.; et al. The evolutionary tale of lilies: Giant genomes derived from transposon insertions and polyploidization. Innovation 2024, 5, 100726. [Google Scholar] [CrossRef]
- Li, Y.Y.; Wang, Y.J.; Xie, Z.K.; Wang, R.Y.; Qiu, Y.; Pan, H.Q.; Hu, J.C. First Report of Lily Blight and Wilt Caused by Fusarium tricinctum in China. Plant Dis. 2013, 97, 993. [Google Scholar] [CrossRef]
- Gao, J.L.; Sun, P.N.; Liang, J.H.; Yang, F.P.; Sun, J.G.; Wang, J.; Zhang, X.H.; Du, Y.P. First Report of Fusarium Wilt on lily (Lilium ‘Tresor’) Caused by Fusarium armeniacum in Jiangsu Province, China. Plant Dis. 2024, 108, 790. [Google Scholar] [CrossRef]
- Li, C.; Li, J.J.; Xue, C.S. Occurence of lily wilt and its control. Acta Phytophylacica Sin. 1994, 21, 135–139. (In Chinese) [Google Scholar]
- Xu, S.J.; Jing, Z.Q.; Guo, Z.J.; Sun, Q. First Report of Root and Bulb Rot Caused by Rhizoctonia solani AG-6 on Lanzhou Lily (Lilium davidii var. unicolor) in China. Plant Dis. 2024, 108, 2218. [Google Scholar] [CrossRef]
- Khan, M.S.; Gao, J.L.; Chen, X.Q.; Zhang, M.F.; Yang, F.P.; Du, Y.P.; Moe, T.S.; Munir, I.; Xue, J.; Zhang, X.H. The Endophytic Bacteria Bacillus velezensis Lle-9, Isolated from Lilium leucanthum, Harbors Antifungal Activity and Plant Growth-Promoting Effects. J. Microbiol. Biotechnol. 2020, 30, 668–680. [Google Scholar] [CrossRef]
- Erazo, J.G.; Palacios, S.A.; Pastor, N.; Giordano, F.D.; Rovera, M.; Reynoso, M.M.; Venisse, J.S.; Torres, A.M. Biocontrol mechanisms of Trichoderma harzianum item 3636 against peanut brown root rot caused by Fusarium solani rc 386. Biol. Control 2021, 164, 104774. [Google Scholar] [CrossRef]
- Chen, Y.F.; Wei, Y.Z.; Cai, B.Y.; Zhou, D.B.; Qi, D.F.; Zhang, M.Y.; Zhao, Y.K.; Li, K.; Wedge, D.E.; Pan, Z.Q.; et al. Discovery of Niphimycin C from Streptomyces yongxingensis sp. nov. as a Promising Agrochemical Fungicide for Controlling Banana Fusarium Wilt by Destroying the Mitochondrial Structure and Function. J. Agric. Food Chem. 2022, 70, 12784–12795. [Google Scholar] [CrossRef] [PubMed]
- Asad, S.A. Mechanisms of action and biocontrol potential of Trichoderma against fungal plant diseases—A review. Ecol Complex. 2022, 49, 100978. [Google Scholar] [CrossRef]
- Yao, X.; Guo, H.L.; Zhang, K.X.; Zhao, M.Y.; Ruan, J.J.; Chen, J. Trichoderma and its role in biological control of plant fungal and nematode disease. Front. Microbiol. 2023, 14, 1160551. [Google Scholar] [CrossRef] [PubMed]
- Dutta, P.; Mahanta, M.; Singh, S.B.; Thakuria, D.; Deb, L.; Kumari, A.; Upamanya, G.K.; Boruah, S.; Dey, U.; Mishra, A.K.; et al. Molecular interaction between plants and Trichoderma species against soil-borne plant pathogens. Front. Plant Sci. 2023, 14, 1145715. [Google Scholar] [CrossRef]
- Vinale, F.; Marra, R.; Scala, F.; Ghisalberti, E.L.; Lorito, M.; Sivasithamparam, K. Major Secondary Metabolites Produced by Two Commercial Trichoderma Strains Active against Different Phytopathogens. Lett. Appl. Microbiol. 2006, 43, 143–148. [Google Scholar] [CrossRef]
- Woo, S.L.; Scala, F.; Ruocco, M.; Lorito, M. The molecular biology of the interactions between Trichoderma spp., Phytopathogenic Fungi, and Plants. Phytopathology 2006, 96, 181–185. [Google Scholar] [CrossRef]
- Woo, S.L.; Ruocco, M.; Vinale, F.; Nigro, M.; Marra, R.; Lombardi, N.; Pascale, A.; Lanzuise, S.; Manganiello, G.; Lorito, M. Trichoderma-based products and their widespread use in agriculture. Open Mycol. J. 2014, 8, 71–126. [Google Scholar] [CrossRef]
- La Spada, F.; Stracquadanio, C.; Riolo, M.; Pane, A.; Cacciola, S.O. Trichoderma Counteracts the Challenge of Phytophthora nicotianae Infections on Tomato by Modulating Plant Defense Mechanisms and the Expression of Crinkler, Necrosis-Inducing Phytophthora Protein 1, and Cellulose-Binding Elicitor Lectin Pathogenic Effectors. Front. Plant Sci. 2020, 11, 583539. [Google Scholar]
- Stracquadanio, C.; Luz, C.; La Spada, F.; Meca, G.; Cacciola, S.O. Inhibition of Mycotoxigenic Fungi in Different Vegetable Matrices by Extracts of Trichoderma Species. J. Fungi 2021, 7, 445. [Google Scholar] [CrossRef]
- Tian, L.; Zhu, X.Y.; Guo, Y.Q.; Zhou, Q.J.; Wang, L.L.; Li, W.L. Antagonism of rhizosphere Trichoderma brevicompactum DTN19 against the pathogenic fungi causing corm rot in saffron (Crocus sativus L.) in vitro. Front. Microbiol. 2024, 15, 1454670. [Google Scholar] [CrossRef]
- Boakye, T.A.; Li, H.X.; Osei, R.; Boamah, S.; Min, Z.; Ni, C.H.; Wu, J.; Shi, M.M.; Qiao, W.Q. Antagonistic Effect of Trichoderma longibrachiatum (TL6 and TL13) on Fusarium solani and Fusarium avenaceum Causing Root Rot on Snow Pea Plants. J. Fungi 2022, 8, 1148. [Google Scholar] [CrossRef] [PubMed]
- Tamandegani, P.R.; Marik, T.; Zafari, D.; Balázs, D.; Vágvölgyi, C.; Szekeres, A.; Kredics, L. Changes in Peptaibol Production of Trichoderma Species during In Vitro Antagonistic Interactions with Fungal Plant Pathogens. Biomolecules 2020, 10, 730. [Google Scholar] [CrossRef] [PubMed]
- Verhage, A.; van Wees, S.C.; Pieterse, C.M. Plant immunity: It’s the hormones talking, but what do they say? Plant Physiol. 2010, 154, 536–540. [Google Scholar] [CrossRef] [PubMed]
- Zhang, Y.L.; Li, X. Salicylic acid: Biosynthesis, perception, and contributions to plant immunity. Curr. Opin. Plant Biol. 2019, 50, 29–36. [Google Scholar] [CrossRef]
- Fang, X.; Xie, Y.; Yuan, Y.; Long, Q.; Zhang, L.; Abid, G.; Zhang, W.Q. The role of salicylic acid in plant defense responses against biotic stresses. Plant Horm. 2025, 1, e004. [Google Scholar] [CrossRef]
- Wang, K.T.; Li, C.H.; Cao, S.F.; Lei, C.Y.; Ji, N.N.; Zou, Y.Y.; Tan, M.L.; Wang, J.S.; Zheng, Y.H.; Gao, H.Y. VOZ-dependent priming of salicylic acid-dependent defense against Rhizopus stolonifer by β-aminobutyric acid requires the TCP protein TCP2 in peach fruit. Plant J. 2025, 121, e17176. [Google Scholar] [CrossRef]
- Shine, M.B.; Yang, J.W.; El-Habbak, M.; Nagyabhyru, P.; Fu, D.Q.; Navarre, D.; Ghabrial, S.; Kachroo, P.; Kachroo, A. Cooperative functioning between phenylalanine ammonia lyase and isochorismate synthase activities contributes to salicylic acid biosynthesis in soybean. New Phytol. 2016, 212, 627–636. [Google Scholar] [CrossRef]
- Cass, C.L.; Peraldi, A.; Dowd, P.F.; Mottiar, Y.; Santoro, N.; Karlen, S.D.; Bukhman, Y.V.; Foster, C.E.; Thrower, N.; Bruno, L.C.; et al. Effects of Phenylalanine Ammonia Lyase (PAL) knockdown on cell wall composition, biomass digestibility, and biotic and abiotic stress responses in Brachypodium. J. Exp. Bot. 2015, 66, 4317–4335. [Google Scholar] [CrossRef]
- Fan, W.H.; Dong, X.N. In vivo interaction between NPR1 and transcription factor TGA2 leads to salicylic acid-mediated gene activation in Arabidopsis. Plant Cell 2002, 14, 1377–1389. [Google Scholar] [CrossRef]
- Ding, Y.L.; Sun, T.J.; Ao, K.; Peng, Y.J.; Zhang, Y.X.; Li, X.; Zhang, Y.L. Opposite Roles of Salicylic Acid Receptors NPR1 and NPR3/NPR4 in Transcriptional Regulation of Plant Immunity. Cell 2018, 173, 1454–1467.e15. [Google Scholar] [CrossRef]
- Hernandez-Escribano, L.; Morales Clemente, M.T.; Fariña-Flores, D.; Raposo, R.A. delayed response in phytohormone signaling and production contributes to pine susceptibility to Fusarium circinatum. BMC Plant Biol. 2024, 24, 727. [Google Scholar] [CrossRef] [PubMed]
- Shi, M.T.; Zhang, T.J.; Fang, Y.; Pan, C.P.; Fu, H.Y.; Gao, S.J.; Wang, J.D. Nano-selenium enhances sugarcane resistance to Xanthomonas albilineans infection and improvement of juice quality. Ecotoxicol. Environ. Saf. 2023, 254, 114759. [Google Scholar] [CrossRef]
- Ghorbel, M.; Brini, F.; Sharma, A.; Landi, M. Role of jasmonic acid in plants: The molecular point of view. Plant Cell Rep. 2021, 40, 1471–1494. [Google Scholar] [CrossRef] [PubMed]
- Zhu, J.; Wang, W.S.; Yan, D.W.; Hong, L.W.; Li, T.T.; Gao, X.; Yang, Y.H.; Ren, F.; Lu, Y.T.; Yuan, T.T. CK2 promotes jasmonic acid signaling response by phosphorylating MYC2 in Arabidopsis. Nucleic Acids Res. 2023, 51, 619–630. [Google Scholar] [CrossRef]
- Zhao, P.Z.; Yang, H.; Sun, Y.W.; Zhang, J.Y.; Gao, K.X.; Wu, J.B.; Zhu, C.R.; Yin, C.C.; Chen, X.Y.; Liu, Q.; et al. Targeted MYC2 stabilization confers citrus Huanglongbing resistance. Science 2025, 388, 191–198. [Google Scholar] [CrossRef]
- Zhang, H.; Zhang, Q.; Zhai, H.; Gao, S.P.; Yang, L.; Wang, Z.; Xu, Y.T.; Huo, J.X.; Ren, Z.T.; Zhao, N.; et al. IbBBX24 Promotes the Jasmonic Acid Pathway and Enhances Fusarium Wilt Resistance in Sweet Potato. Plant Cell 2020, 32, 1102–1123. [Google Scholar] [CrossRef] [PubMed]
- Du, W.T.; Chai, N.; Sun, Z.Q.; Wang, H.R.; Liu, S.X.; Sui, S.Z.; Luo, L.; Liu, D.F. Full-Length Transcriptome Characterization and Functional Analysis of Pathogenesis-Related Proteins in Lilium Oriental Hybrid ‘Sorbonne’ Infected with Botrytis elliptica. Int. J. Mol. Sci. 2022, 24, 425. [Google Scholar] [CrossRef]
- Wang, W.J.; Cao, H.H.; Wang, J.H.; Zhang, H.B. Recent advances in functional assays of WRKY transcription factors in plant immunity against pathogens. Front. Plant Sci. 2025, 15, 1517595. [Google Scholar] [CrossRef]
- Yang, L.; Fang, S.Y.; Liu, L.; Zhao, L.R.; Chen, W.Q.; Li, X.; Xu, Z.Y.; Chen, S.D.; Wang, H.P.; Yu, D.Q. WRKY transcription factors: Hubs for regulating plant growth and stress responses. J. Integr. Plant Biol. 2025, 67, 488–509. [Google Scholar] [CrossRef]
- Li, M.Y.; Zhao, S.Q.; Yang, J.Y.; Ren, Y.; Su, J.; Zhao, J.J.; Ren, X.P.; Wang, C.Y.; Chen, S.S.; Yu, X.M.; et al. Exogenous expression of barley HvWRKY6 in wheat improves broad-spectrum resistance to leaf rust, Fusarium crown rot, and sharp eyespot. Int. J. Biol. Macromol. 2022, 218, 1002–1012. [Google Scholar] [CrossRef]

| Fungicides | Concentrations (mg/L) |
|---|---|
| TKs | 5, 10, 20, 40, 80 |
| matrine | 2.5, 5, 10, 20, 40 |
| hymexazol | 20, 40, 80, 160, 320 |
| Disease Levels | Leaf-Withering Degree |
|---|---|
| 0 | <10% |
| 1 | 10–20% |
| 2 | 21–30% |
| 3 | 31–50% |
| 4 | 51–70% |
| 5 | 71–100% |
| Primers | Sequences (5′-3′) |
|---|---|
| LzICS1-F | CTGCCGGGGTGTTACTTCTC |
| LzICS1-R | TCCAGTCCTGCAAGCCAAA |
| LzNPR1-F | CTTGATAAGTTCTTGGAGGACGAT |
| LzNPR1-R | GATGTAGACGATGAGGACGATGAT |
| LzPR1-F | GCCACTACACGCAGGTTGTG |
| LzPR1-R | GCCTCTCGCCGACGTTATTC |
| LzJAR1-F | CGTCGGAAGGATGGATTGGT |
| LzJAR1-R | TCAAACCAACTGGCTCTGCT |
| LzAOS-F | GCCTCCAGTGTGTCGGACTTC |
| LzAOS-R | GGCAGCGGGAATGTGTGTAGA |
| LzMYC2-F | CACTCCTTGGTGATGCCATCGC |
| LzMYC2-R | CATTGCCCATGCCGCCGTTC |
| LzChi2-F | TTTCCAGTTCTACGCCTATGCTG |
| LzChi2-R | CGGTACTTGCTGAAGTGAAGCTC |
| LzPAL2-F | CCTGTCACCAACCACGTTCAGAG |
| LzPAL2-R | CACTGCCTCCGCTGTCTTCCT |
| LzWRKY75-F | GATCCTCCGAAACCAATGCCA |
| LzWRKY75-R | CAGCGATAGCCGTCGTCAAG |
| LzWRKY26-F | AATACATCAGCAGCATAGG |
| LzWRKY26-R | CTCCACCTTCTTCTTCATC |
| Pathogens | Fungicides | Mycelial Growth | Spore Germination | ||||
|---|---|---|---|---|---|---|---|
| Regression Equation (Y=) | Correlation Coefficient (r) | EC50 (mg·L−1) | Regression Equation (Y=) | Correlation Coefficient (r) | EC50 (mg·L−1) | ||
| F. oxysporum | 99% hymexazol WP | 1.740x − 2.602 | 0.985 | 31.3 a | 1.622x − 3.159 | 0.985 | 88.5 a |
| 0.3% matrine EC | 2.260x − 1.667 | 0.864 | 5.5 b | 3.342x − 3.094 | 0.964 | 8.4 c | |
| 0.5% trichokonins SL | 1.559x − 2.332 | 0.943 | 31.3 a | 1.370x − 2.071 | 0.993 | 32.5 b | |
| F. solani | 99% hymexazol WP | 1.792x − 4.336 | 0.941 | 263.0 a | 2.053x − 3.168 | 0.998 | 34.9 a |
| 0.3% matrine EC | 2.870x − 1.100 | 0.975 | 2.4 c | 2.913x − 1.544 | 0.972 | 3.4 c | |
| 0.5% trichokonins SL | 1.052x − 1.850 | 0.980 | 57.3 b | 1.907x − 2.100 | 0.998 | 12.6 b | |
Disclaimer/Publisher’s Note: The statements, opinions and data contained in all publications are solely those of the individual author(s) and contributor(s) and not of MDPI and/or the editor(s). MDPI and/or the editor(s) disclaim responsibility for any injury to people or property resulting from any ideas, methods, instructions or products referred to in the content. |
© 2025 by the authors. Licensee MDPI, Basel, Switzerland. This article is an open access article distributed under the terms and conditions of the Creative Commons Attribution (CC BY) license (https://creativecommons.org/licenses/by/4.0/).
Share and Cite
Cao, X.; Liang, J.; Wu, Z.; Zhang, M.; Li, H.; Liu, T.; Yue, W.; Wang, Y.; Jiang, L.; Wang, G.; et al. Biocontrol Mechanisms of Trichoderma longibrachiatum SMF2 Against Lanzhou Lily Wilt Disease Caused by Fusarium oxysporum and Fusarium solani. Horticulturae 2025, 11, 660. https://doi.org/10.3390/horticulturae11060660
Cao X, Liang J, Wu Z, Zhang M, Li H, Liu T, Yue W, Wang Y, Jiang L, Wang G, et al. Biocontrol Mechanisms of Trichoderma longibrachiatum SMF2 Against Lanzhou Lily Wilt Disease Caused by Fusarium oxysporum and Fusarium solani. Horticulturae. 2025; 11(6):660. https://doi.org/10.3390/horticulturae11060660
Chicago/Turabian StyleCao, Xing, Jiahui Liang, Ze Wu, Mingshun Zhang, Haiyan Li, Tao Liu, Wenxiu Yue, Yanan Wang, Liangbao Jiang, Guiqing Wang, and et al. 2025. "Biocontrol Mechanisms of Trichoderma longibrachiatum SMF2 Against Lanzhou Lily Wilt Disease Caused by Fusarium oxysporum and Fusarium solani" Horticulturae 11, no. 6: 660. https://doi.org/10.3390/horticulturae11060660
APA StyleCao, X., Liang, J., Wu, Z., Zhang, M., Li, H., Liu, T., Yue, W., Wang, Y., Jiang, L., Wang, G., Zhao, P., Zhou, Y., Chen, X., Sui, J., Hou, D., Song, X., & Zhang, X. (2025). Biocontrol Mechanisms of Trichoderma longibrachiatum SMF2 Against Lanzhou Lily Wilt Disease Caused by Fusarium oxysporum and Fusarium solani. Horticulturae, 11(6), 660. https://doi.org/10.3390/horticulturae11060660

